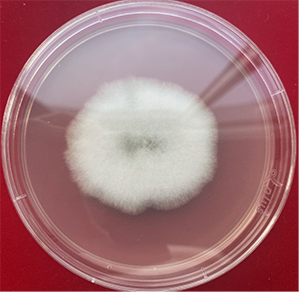

市农科院在无花果黑点病研究方面取得重要进展
文章来源:威海市农业农村局
时间:
2021-05-28 11:25
点击次数:
无花果是威海市重要的特色水果之一,其栽培面积已经达到了近5万亩,成为威海市仅次于苹果的第二大水果种类。无花果已经成为威海等地区农民增收的重要经济支柱产业。
在无花果生产中,无花果黑点病的防治是当前生产中存在的一个关键技术难题。无花果黑点病致病原因不明,有人说为生理性碳化病害,有人说是细菌性病害,也有人说为真菌性病害等。该病害不仅造成无花果叶片坏死甚至脱落,而且严重影响了无花果的内在和外在品质。特别是无花果果实感染黑点病后,果实外观质量下降,直接影响了无花果的销售价格,使农民种植无花果的收益大幅下降。该病害已经成为威海无花果果农和地方政府关心的重要问题。
为解决生产中的实际问题,在国家苹果产业技术体系和精致农业研究院经费的支持下,威海市农科院农艺师丁荔对威海无花果黑点病致病原因进行了系统研究,在确定无花果黑点病越冬菌源的基础上,多次对致病菌菌进行分离纯化,共分离到7种病菌,经过病菌培养,并在无花果枝条和果实上接种,编号为04、05的真菌在无花果枝条和果实上可以造成侵染,致病症状与无花果黑点病基本一致,初步确定为无花果黑点病致病菌。这一发现为无花果黑点病的防控提供了重要理论基础。
目前,市农科院研究人员正在对该病菌进行形态学和分子生物学鉴定,以确定该致病真菌种属,下一步将对分离到的无花果黑点病真菌进行药剂敏感性测试和筛选。在完成以上工作的基础上,市农科院将组织专家对该成果进行鉴定。
(夏营、曹洪建)